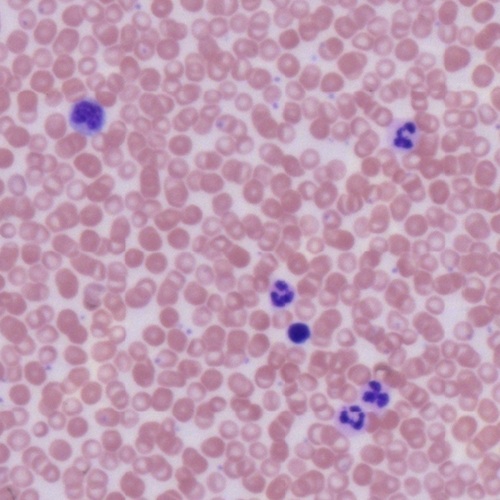
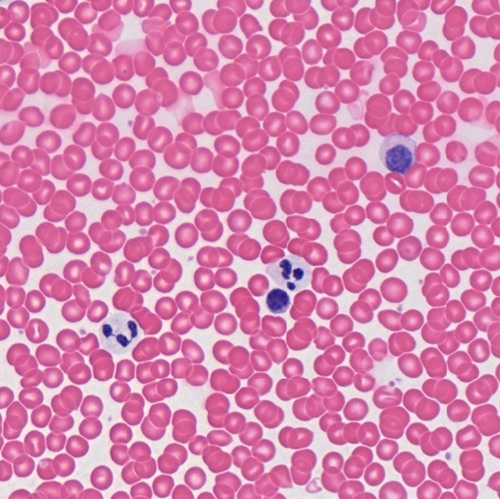
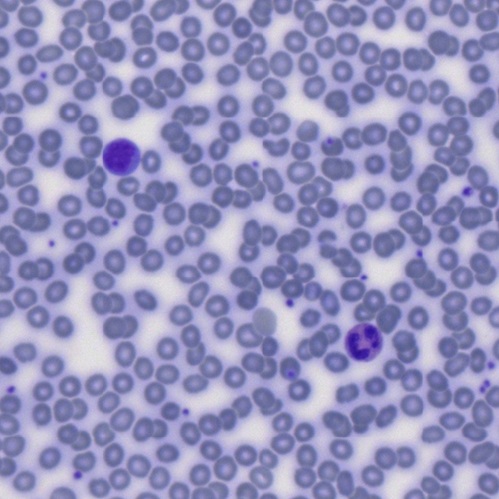
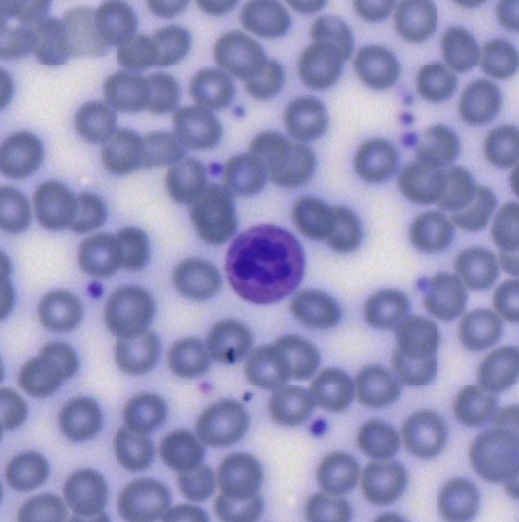
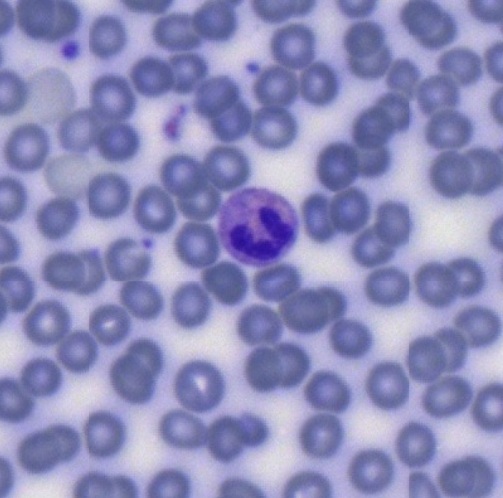
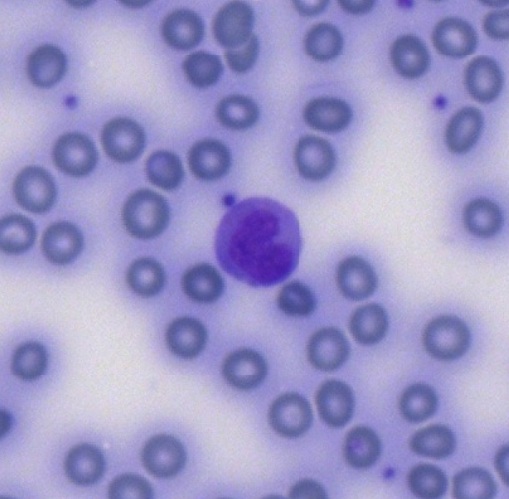
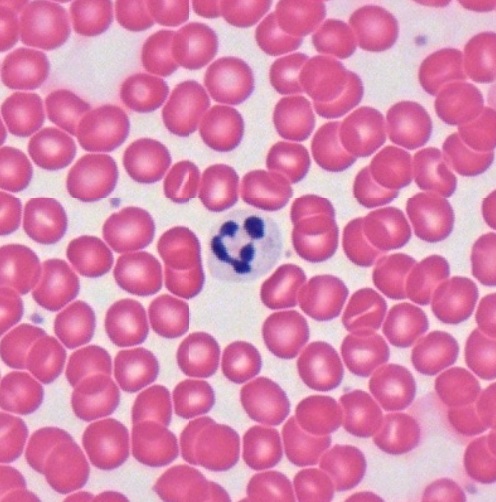
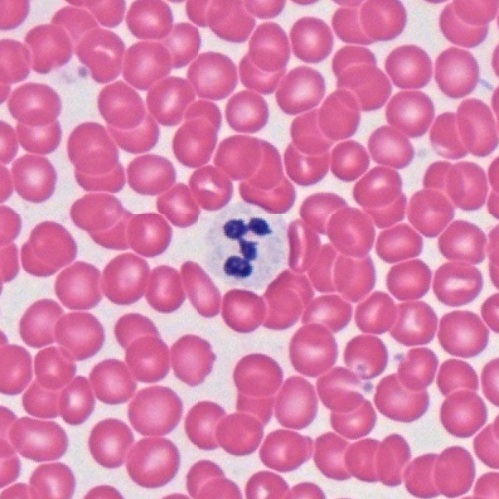
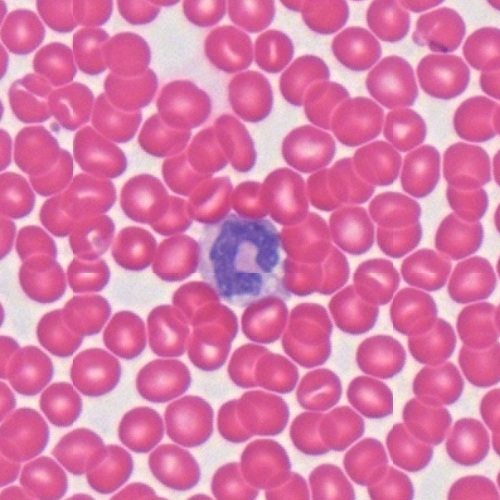
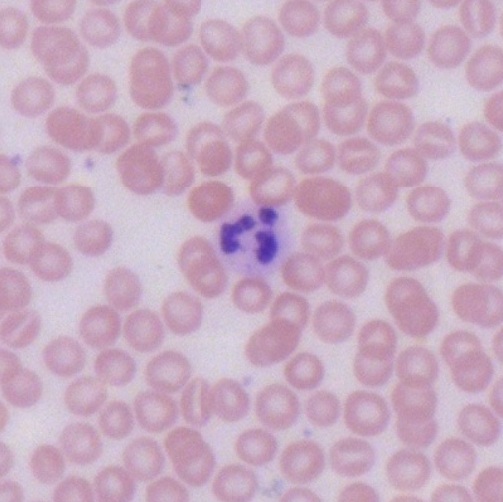
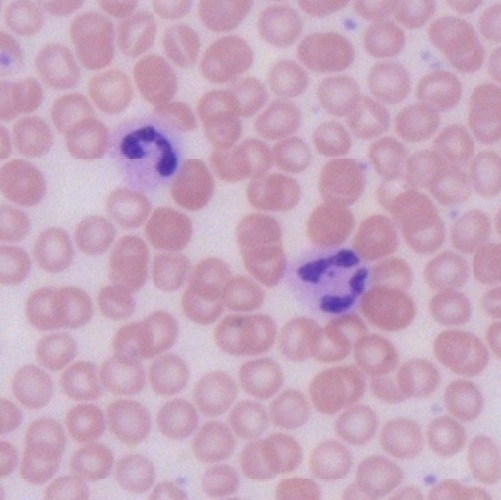
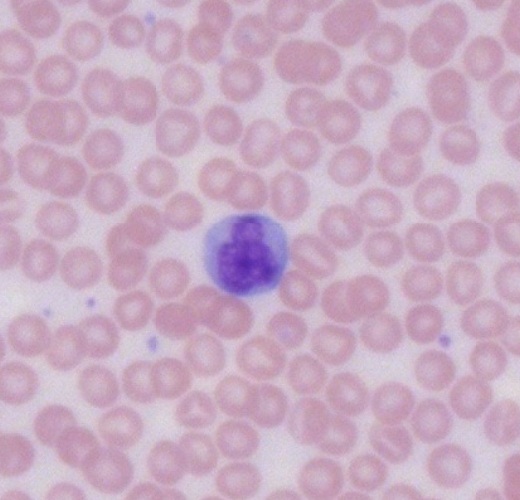
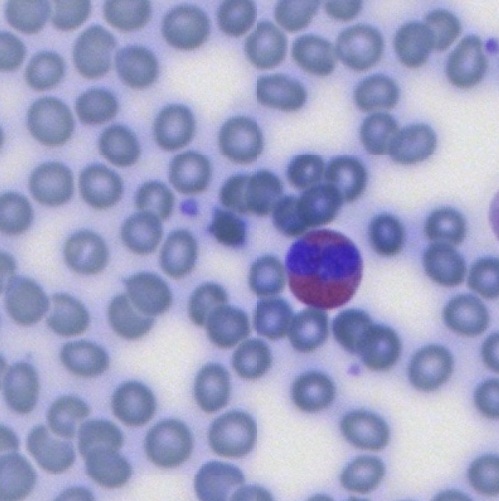
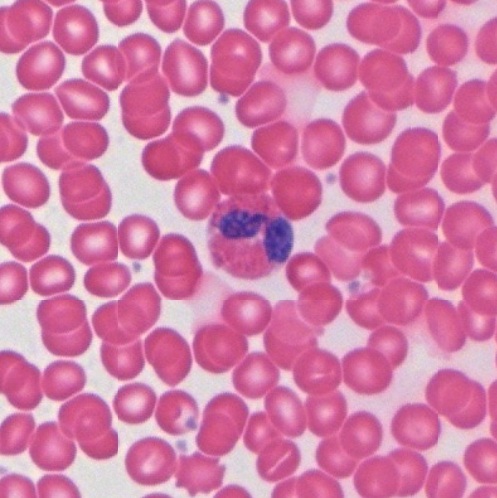
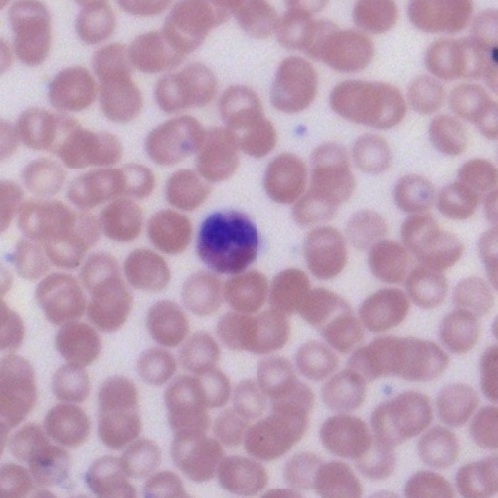
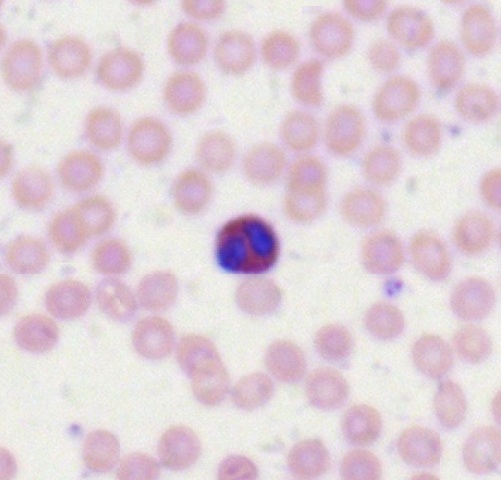
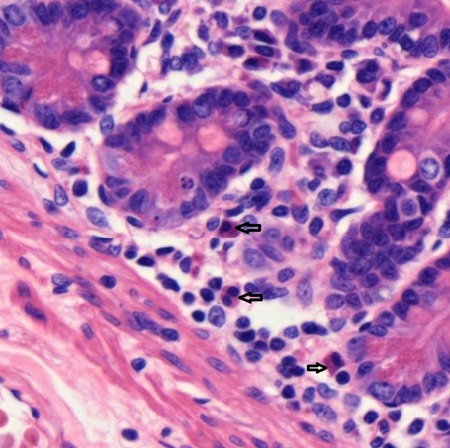
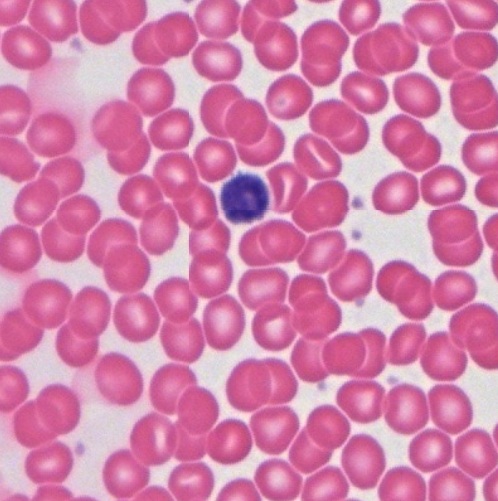
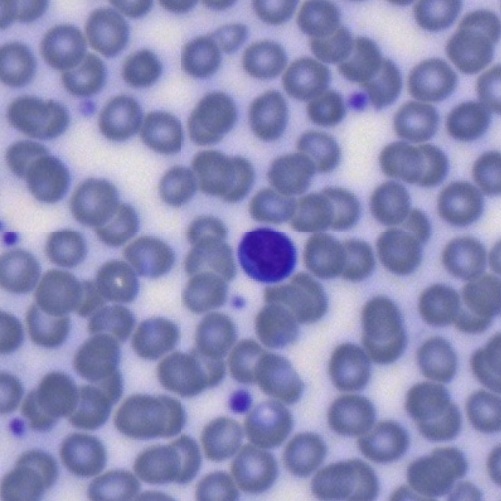
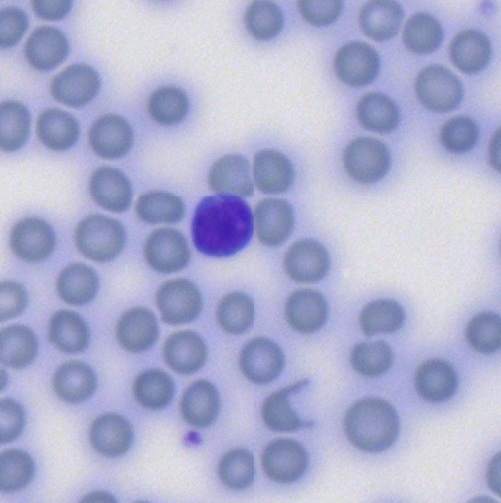
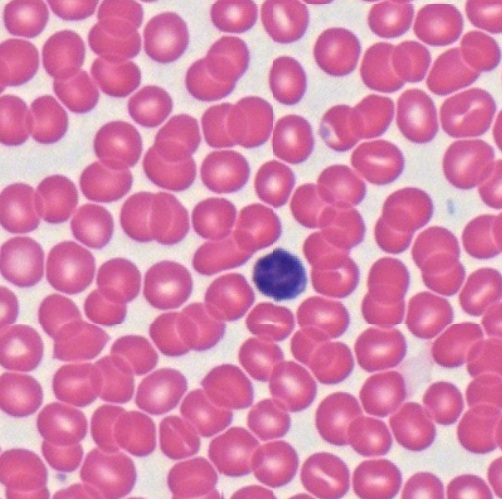
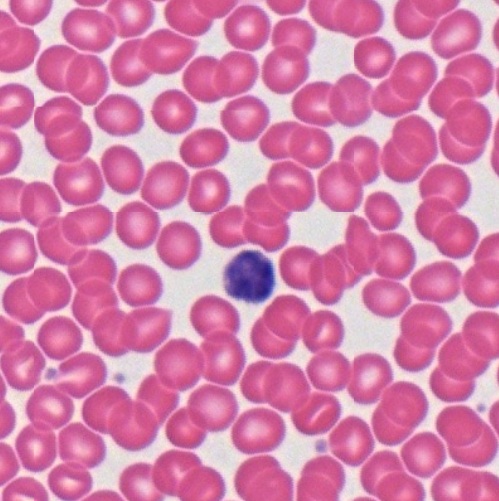
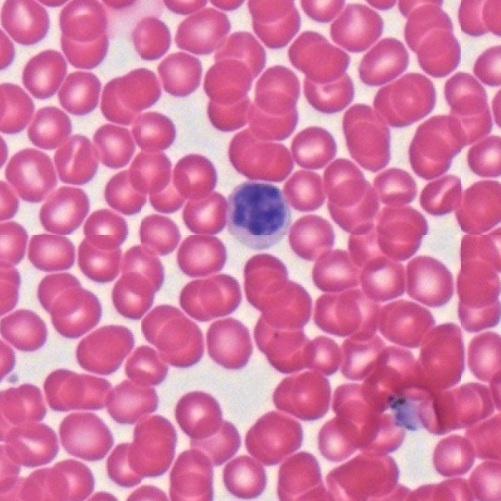
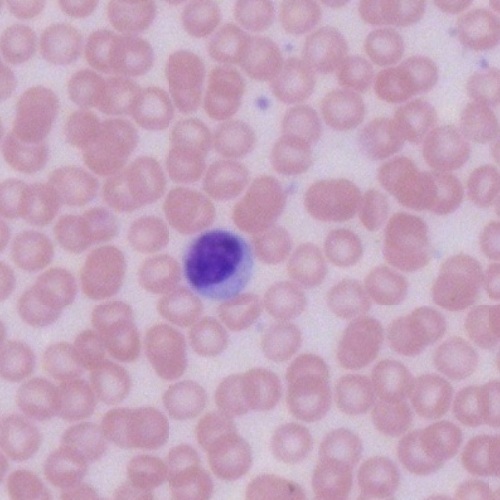
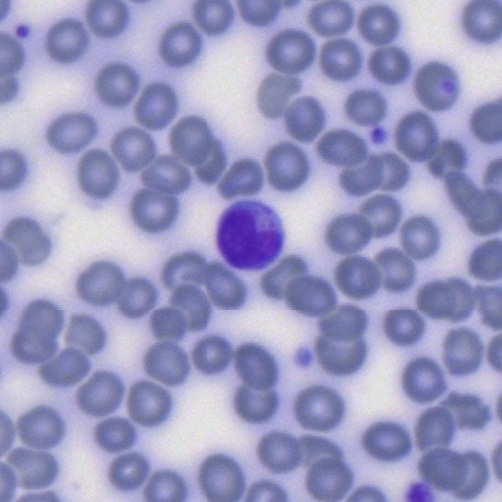
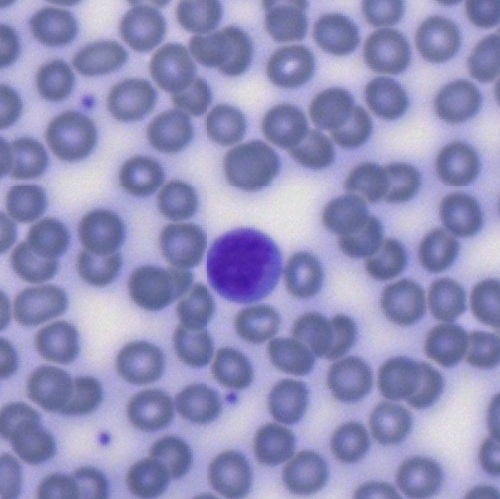
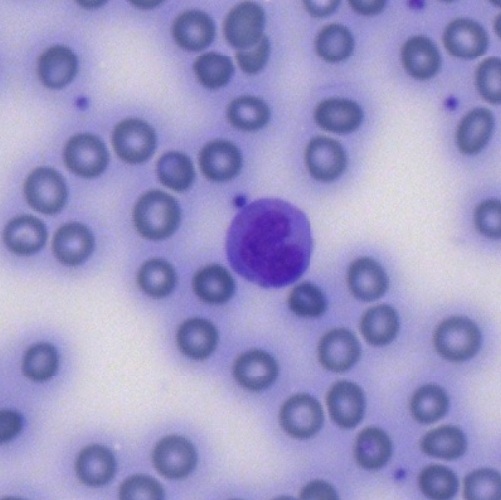
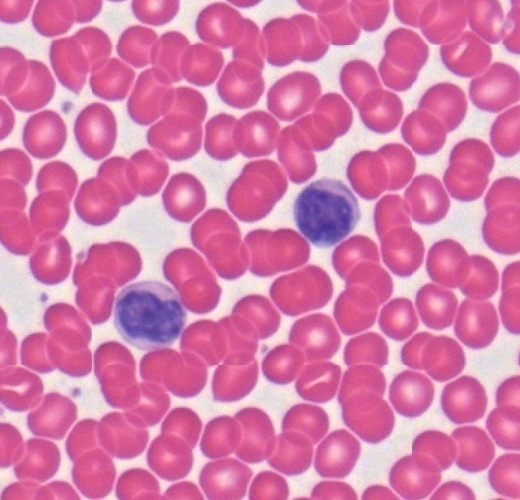
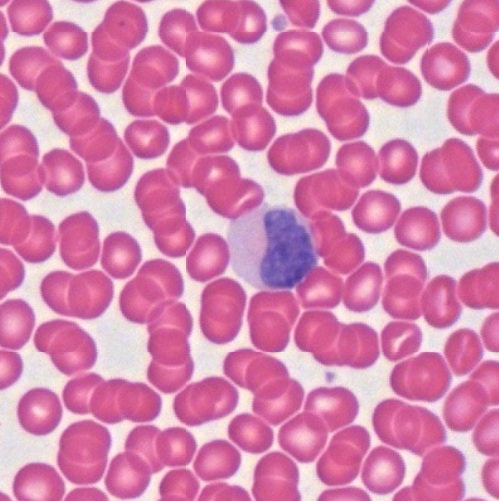
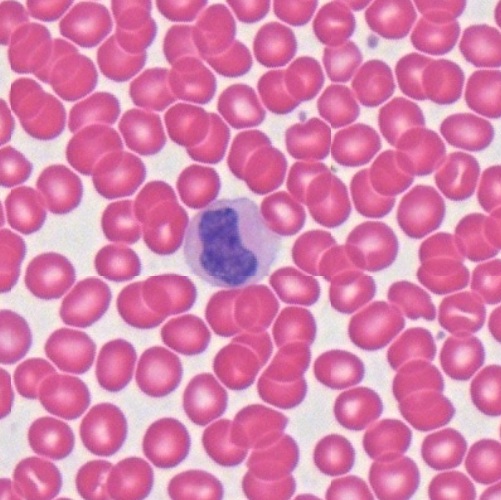
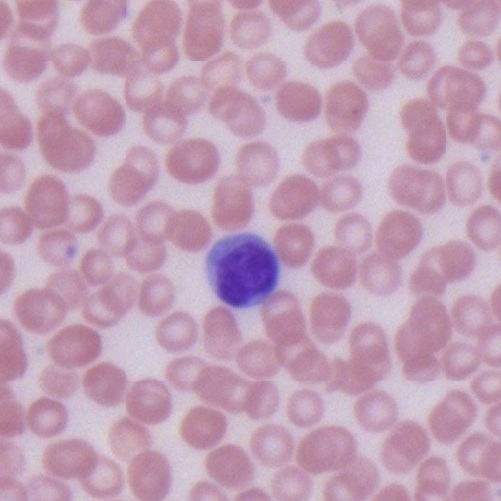
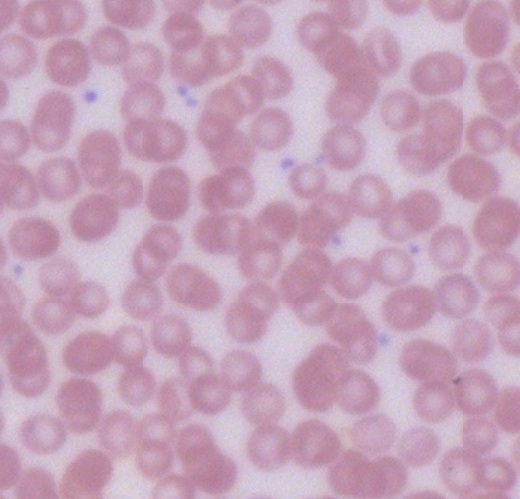
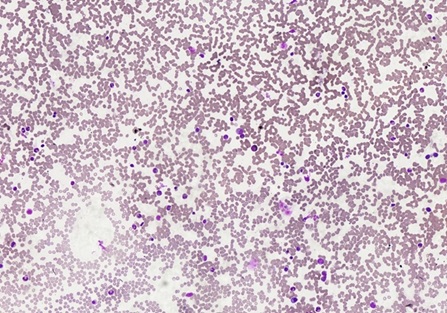
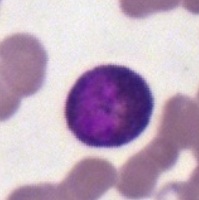
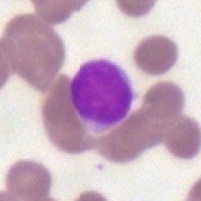
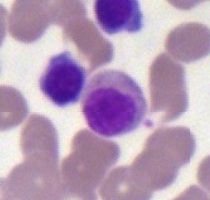
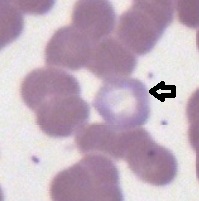
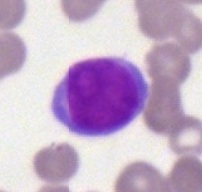
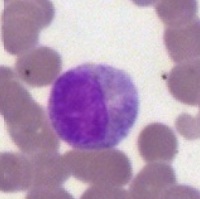
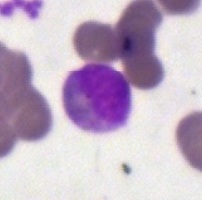
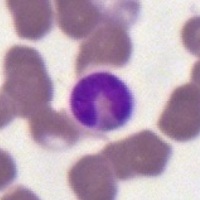
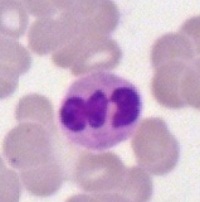
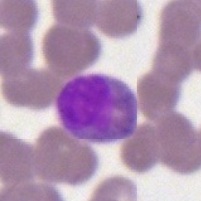
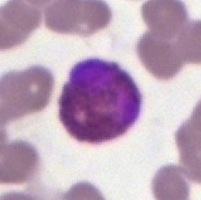
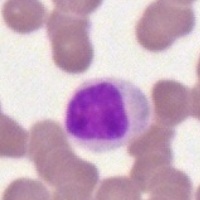
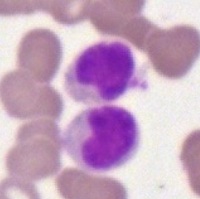
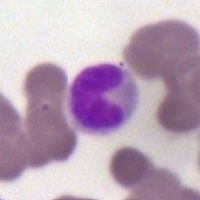
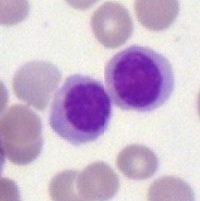
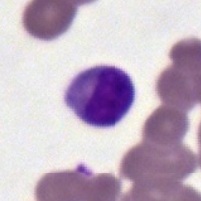

Blood is a specialized type of connective tissue, composed of red blood cells, white blood cells, cell fragments (platelets), and plasma, a fluid extracellular element. It circulates throughout the body within an organization of vessels, including arteries, veins, and capillaries with rive force coming from continuous pumping of the heart. All blood cells develop from a single pluripotential hemopoietic stem cell. Most of these pluripotential hemopoietic stem cells and other hemopoietic stem cells of adults are located in the red bone marrow of short and flat bone. Smear is a common preparation with either Wright stain or Giemsa stain used to observe blood cells and hemopoietic stem cells. Occasionally the routine hematoxylin-eosin stain is also used.
Red Blood Cell (RBC)
It is also known as erythrocyte and is the only unnucleated cell type in human body. The loss of nuclei of erythrocytes during formation make them to be a biconcave disc shape with a pale stained central region. Their cytoplasm is eosinophilic or acidophilic and stained pink by Giemsa stain (Fig. 5-1), rose red by hematoxylin-eosin stain (Fig. 5-2), and stained blue gray by Wright stain (Fig. 5-3).
In sections of blood vessels, no matter of artery (Fig. 5-4), vein (Fig. 5-5), or capillary (Fig. 5-6), erythrocytes are found to be biconcave disc shape or dumbbell shape due to cutting. It reveals that the diameter (6-8 μm) of erythrocyte is almost the same as the thickness (7-10 μm) of a paraffin section used for light microscopic observation.
White Blood Cell (WBC)
It is also known as leukocyte. There are five types of leukocytes in normal blood circulation, which are further classified into two main groups, granulocytes and mononuclear leukocytes, based on their nuclear shape and cytoplasmic granules.
Granulocytes
Granulocytes are named for their cytoplasmic secretory granules. There are three types of granulocytes including neutrophils, eosinophils, and basophils based on their staining characteristics of the specific granules. They have a single multilobed nucleus and had been erroneously named polymorphonuclear leukocytes or polymorph before by early microscopists. Due to their exclusive origin from bone marrow, they are referred to as myeloid cells.
Neutrophils
Neutrophils are the most common type of leukocytes in blood and constitute 40-75% of circulating leukocytes depending on if they are in the acute inflammatory response to tissue injury. The most prominent feature of the neutrophil is the highly lobulated nucleus. As seen in smear preparation stained by Wright stain (Figs. 5-7 ~ 5-10), hematoxylin-eosin stain (Figs. 5-11 ~ 5-14), and Giemsa stain (Figs. 5-15 ~ 5-18), nucleus of a mature neutrophil usually has five lobes connected by fine strands of nuclear material (Figs. 5-7, 5-11, and 5-15). In less mature neutrophils have less than five lobes of nuclei (Figs. 5-8, 5-9, 5-12, 5-13, 5-16, 5-17) or even not as lobulated (Figs. 5-10, 5-14, and 5-18). Except the lobulated nucleus, the cytoplasm of neutrophils is highly stippled with purplish granules which are more visible in blood smear stained by Wright stain (Figs. 5-7 ~ 5-10).
Eosinophils
Eosinophils account for 1-6% of leukocytes in circulating blood. Their numbers are greatest in the morning and least in the afternoon. Eosinophil is larger than neutrophil. It has a diameter of 12-17 μm and contains large specific granules stained brick red by Wright stain (Fig. 5-19), hematoxylin and eosin (Fig. 5-20), or Giemsa stain (Fig. 5-21 and 5-22). Most eosinophils have a bilobed nucleus, sometime obscured by densely packed granules.
The majority of eosinophils (arrow) are only present in blood for hours then enter the skin (Fig. 5-23), mucosa of pulmonary tract (Fig. 5-24), and gastrointestinal tract (Fig. 5-25) in response to injury or bacterial invasion.
Basophils
Basophils are the least common leukocyte and constitute less than 1% of leukocytes in circulating blood. They have large intensively basophilic granules in cytoplasm. As seen in smear preparation stained by Wright stain (Fig. 5-26), hematoxylin-eosin stain (Fig. 5-27), and Giemsa stain (Fig. 5-28), these granules usually obscure appearance of the nucleus. Basophil has a diameter of 14-16 μm, intermediate size between neutrophil and eosinophil. It is the precursor of the mast cell (Fig. 5-29). Both share many structural and functional similarity.
There are two types of mononuclear leukocytes, lymphocytes and monocytes. The term “mononuclear leukocyte” is used to distinguish from “polymorph” having multilobed nucleus. Both lymphocytes and monocytes have non-lobulated nuclei. They are also called agranulocytes to distinguish from granulocytes.
Lymphocytes
Lymphocytes are the smallest leukocytes with a variation of sizes depending on the activity. The small inactive lymphocytes are 6-9 μm in diameter, while the large active lymphocytes are 9-15 μm in diameter and make up only 3% of total lymphocytes. They have a round, densely stained nucleus with a relatively small amount of pale basophilic, non-granular cytoplasm. In smear preparations stained by Wright stain (Figs. 5-30 ~ 5-32), hematoxylin-eosin stain (Figs. 5-33 ~ 5-35), and Giemsa stain (Figs. 5-36 ~ 5-38), various lymphocytes can be observed.
Monocytes
Monocytes are the largest leukocytes and have a size up to 20 μm in diameter. They constitute 2 to 10% of leukocytes in peripheral blood. XXX In smear preparations stained by Wright stain (Figs. 5-39 ~ 5-41), hematoxylin-eosin stain (Figs. 5-42 ~ 5-44), and Giemsa stain (Figs. 5-45 ~ 5-47), various lymphocytes can be observed.
Platelets
Different from erythrocytes and leukocytes, platelets (Figs. 5-48 ~ 5-50), also known as thrombocytes, are small, non-nucleated cell fragments formed from the cytoplasm of the huge megakaryocytes (Fig. 5-51) in bone marrow.
Hemopoiesis
It is a process of blood cell formation and development, also known as hematopoiesis. All blood cells arise from hematopoietic stem cells, also known as hemocytoblasts. Then, two cell lineages are developed as myeloid progenitor and lymphoid progenitor. Eventually, the myeloid progenitor will develop into erythrocytes, three granulocytes, monocytes, and platelets in blood. Lymphocytes are the only blood cells derived from lymphoid progenitor. During embryo development, blood formation occurs in aggregates of blood cells in the yolk sac, called blood islands. As development progresses, blood formation occurs in the spleen, liver and lymph nodes. Once bone marrow develops, it eventually assumes the task of forming most of the blood cells. However, maturation, activation, and some proliferation of lymphoid cells occur in the spleen, thymus, and lymph nodes. In children, hematopoiesis occurs in the marrow of the long bones such as the femur and tibia. In adults, it occurs mainly in the pelvis, cranium, vertebrae, and sternum.
Two kinds of marrow tissues can be recognized by color. Red marrow is highly active due to the predominance of maturing erythrocytes. Yellow marrow is less active due to increasing amount of fat cells. However, the yellow marrow can be reactivated if the need arises for increased hematopoiesis. In a section of adult bone marrow stained by hematoxylin and eosin (Fig. 5-52), cellular elements can be observed. Many adventitial reticular cells or adipose cells (A) are found (Fig. 5-53). All developing stages of erythrocytes and leukocytes can also be found but are not easy to identify except the large multinucleated megakaryocytes (M). Sinusoid (S) are found to contain mature erythrocytes (Fig. 5-54). Blood vessel (V) can also be found in the marrow (Fig. 5-55).
A marrow smear stained by Giemsa stain is usually used to reveal developing stages of erythrocytes and leukocytes (Fig. 5-56).
The developing stages of erythrocytes include proerythroblast (Fig. 5-57), basophilic erythroblast (Fig. 5-58), polychromatophilic erythroblast (Fig. 5-59), orthochromatophilic erythroblast (Fig. 5-60), reticulocyte (Fig. 5-61), and mature erythrocyte (Fig. 5-62).
The developing stages of neutrophil include myeloblast (Fig. 5-63), promyelocyte (Fig. 5-64), neutrophilic myelocyte (Fig. 5-65), neutrophilic metamyelocyte (Fig. 5-66), neutrophil stab cell (Fig. 5-67), and mature neutrophil (Fig. 5-68).
The developing stages of eosinophil include myeloblast (Fig. 5-63), promyelocyte (Fig. 5-64), eosinophilic myelocyte (Fig. 5-69), eosinophilic metamyelocyte (Fig. 5-70), and mature eosinophil (Fig. 5-71).
The developing stages of monocytes include monoblast (Fig. 5-72), promonocyte (Fig. 5-73), and mature monocyte (Fig. 5-74).
The developing stages of lymphocytes include lymphoblast (Fig. 5-75), prolymphocyte (Fig. 5-76), and mature lymphocyte (Fig. 5-77).
NOTE:
- Only those structures visible under the light microscope are discussed here. It is suggested that to study all structures visible under the electron microscope through your histology textbook and atlas.
- All photos used for discussion are taken from DSMH digital slides as follows:
H030031 Mast Cells, wm. of mesentery, mammal, MB. (Fig. 5-29)
H060010 Human Blood, smear, GS. (Figs. 5-1, 5-15, 5-16, 5-17, 5-18, 5-21, 5-22, 5-28, 5-36, 5-37, 5-38, 5-45, 5-46, 5-47, 5-50,
H060011 Human Blood, smear, WR. (Figs. 5-3, 5-7, 5-8, 5-9, 5-10, 5-19, 5-26, 5-30, 5-31, 5-32, 5-39, 5-40, 5-41, 5-48,
H060012 Human Blood, smear, HE. (Figs. 5-2, 5-11, 5-12, 5-13, 5-14, 5-20, 5-27, 5-33, 5-34, 5-35, 5-42, 5-43, 5-44, 5-49,
H070090 Bone Marrow, sec., human, HE. (Figs. 5-51, 5-52, 5-53, 5-54, 5-55)
H070091 Bone Marrow, smear, human, GS. (Figs. 5-56, 5-57, 5-58, 5-59, 5-60, 5-61, 5-62, 5-63, 5-64, 5-65, 5-66, 5-67, 5-68, 5-69, 5-70, 5-71, 5-72, 5-73, 5-74, 5-75, 5-76, 5-77)
H080020 Thin Skin, sec. of facial skin, human, HE. (Fig. 5-23)
H090200 Duodenum, cs., human, HE. (Figs. 5-4, 5-4, 5-6, 5-25)
H100020 Trachea, cs., human, HE. (Fig. 5-24) - Staining methods and results:
GS = Giemsa stain, commonly used for staining blood smears to differentiate and examine various blood cells.
HE = hematoxylin and eosin, used to stain cell nuclei blue and cytoplasm pink or red. Hematoxylin may also stain ribosomes and rough endoplasmic reticulum blue.
MB = methylene blue, used to stain rough endoplasmic reticulum blue.
WR = Wright stain, used to differentiate blood cell types.